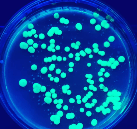
Colonias de bacterias fluorescentes

| Título | Un fogar para todos |
|---|---|
| Descrición | REA Un fogar para todos da materia Bioloxía e Xeoloxía de 1º de Educación Secundaria Obrigatoria Este REA céntrase na adquisición dos contidos relacionados coas unidades "A Terra, un planeta vivo" e "A diversidade dos seres vivos". Para poder traballar aspectos curriculares propios da materia, contextualizamos este REA nunha situación real de aprendizaxe na cal o alumnado terá que crear un calendario da Biodiversidade centrado nunha zona natural de interese próxima. Anímase á divulgación do produto final na comunidade educativa, local e autonómica. |
| Autoría |
María Jesús Fuentes Silveira Carlos de Paz Villasenín Lois Anxo Rodríguez Calvo |
| Organización |
Dirección Xeral de Ordenación e innovación Educativa. Consellería de Cultura, Educación, Formación Profesional e Universidades. Xunta de Galicia. |
| Licenza | Licencia Creative Commons Reconocimiento No comercial Compartir igual 4.0 |
| Identificación |
"Un fogar para todos!" ; ISSN (web): 3101-0040 |
Este contenido foi creado con eXeLearning,

.jpg)









.jpg)




.jpg)















































